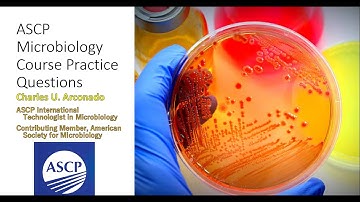
ASCP Microbiology Course PRACTICE QUESTIONS

⬇ DOWNLOAD NOW
Kalau muncul iklan pop-up, tutup lalu klik tombol kembali
Download lagu MLS ASCP Exam Recall Questions Correct Answers Latest Updated Graded A 636x882 secara gratis hanya untuk keperluan promosi. Dukung artis favorit kamu dengan membeli musik original di iTunes atau platform resmi lainnya.
 MLS ASCP EXAM LATEST 2025/2026 ACTUAL EXAM WITH COMPLETE QUESTIONS AND CORRECT DETAILED ANSWERS
MLS ASCP EXAM LATEST 2025/2026 ACTUAL EXAM WITH COMPLETE QUESTIONS AND CORRECT DETAILED ANSWERS
 “Test Your Clinical Chemistry Knowledge in 1 Minute! ⏱️”
“Test Your Clinical Chemistry Knowledge in 1 Minute! ⏱️”
 BOC MLS ASCP EXAM LATEST 20252026 ACTUAL EXAM WITH COMPLETE QUESTIONS AND CORRECT DETAILED ANSWERS 1
BOC MLS ASCP EXAM LATEST 20252026 ACTUAL EXAM WITH COMPLETE QUESTIONS AND CORRECT DETAILED ANSWERS 1
 MLS Medical Laboratory Scientist ASCP Exam 2025 Questions and Answers
MLS Medical Laboratory Scientist ASCP Exam 2025 Questions and Answers
ASCP Microbiology Course PRACTICE QUESTIONS
ASCP Microbiology Course PRACTICE QUESTIONS
 ASCP Exam. RMT Exam recall. #medtech #medtechstudent #coagulation #rmt #ascp
ASCP Exam. RMT Exam recall. #medtech #medtechstudent #coagulation #rmt #ascp
 ASCP/RMT Exam Recall. #medtech #medtechstudent #ascp #rmt #shortsyoutube #shortvideoyoutube #foryou_
ASCP/RMT Exam Recall. #medtech #medtechstudent #ascp #rmt #shortsyoutube #shortvideoyoutube #foryou_
 ASCP Exam. RMT Exam recall. #medtech #medtechstudent #shortvideos #shortsyoutube #rmt #ascp #foryouシ
ASCP Exam. RMT Exam recall. #medtech #medtechstudent #shortvideos #shortsyoutube #rmt #ascp #foryouシ